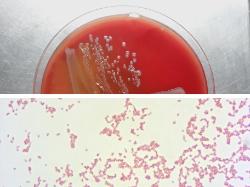

| E. fergusonii colonies on sheep blood agar (up) and Gram-negative short rods (down) |
| Escherichia fergusonii |
Taxonomy
Morphology
Cultural characteristics
Biochemical characters
Ecology
Pathogenicity
References
Phylum Pseudomonadota (Proteobacteria), Class Gammaproteobacteria, Order Enterobacterales, Family Enterobacteriaceae,
Genus Escherichia, Escherichia fergusonii Farmer et al. 1985.
Genus Escherichia, Escherichia fergusonii Farmer et al. 1985.
Gram-negative, 0.5-1.5 x 2.0-6.0 μm, straight, bacilli or coccobacilli. Non-spore-
forming. Usually motile.
forming. Usually motile.
Colonies on Nutrient agar may be smooth (S type), low convex, shiny surface, entire
edge and non-pigmented. Aerobic, facultatively anaerobic. Optimum growth
temperature 37 ºC. Grow readily on simple nutrient media like Nutrient agar or
nutrient broth. It produce lactose-negative colonies on selective agar. No growth on
KCN medium.
edge and non-pigmented. Aerobic, facultatively anaerobic. Optimum growth
temperature 37 ºC. Grow readily on simple nutrient media like Nutrient agar or
nutrient broth. It produce lactose-negative colonies on selective agar. No growth on
KCN medium.
Isolated from various domestic and migratory birds, pigs, cattle, sheep, goats,
equines, humans and foods of animal origin.
equines, humans and foods of animal origin.
E. fergusonii is regarded as an emerging pathogen with zoonotic potential. In humans, it was implicated in wound infections,
diarrhea, endophtalmitis, cystitis, bacteremia, urinary tract infections and haemolytic uremic syndrome. In animals, E. fergusonii was
identified from fibrino-necrotic typhlitis in ostrich, diarrheic caprines and equines, pneumonia in bovines and abortion, mastitis,
diarrhoea in cattle and sheep. Avian and porcine strains can carry a high number of antimicrobial resistance genes, while the
pathogenic potential of bovine strains is higher. This bacteria can possess multiple virulence factors, such as heat-labile toxin,
heat-stable toxin and products of eae (intimine), iss, prfB and ireA genes.
diarrhea, endophtalmitis, cystitis, bacteremia, urinary tract infections and haemolytic uremic syndrome. In animals, E. fergusonii was
identified from fibrino-necrotic typhlitis in ostrich, diarrheic caprines and equines, pneumonia in bovines and abortion, mastitis,
diarrhoea in cattle and sheep. Avian and porcine strains can carry a high number of antimicrobial resistance genes, while the
pathogenic potential of bovine strains is higher. This bacteria can possess multiple virulence factors, such as heat-labile toxin,
heat-stable toxin and products of eae (intimine), iss, prfB and ireA genes.
- J. G. Holt et al., 1994. Facultatively Anaerobic Gram-Negative Rods. Subgroup 1. Family Enterobacteriaceae. In: Begey’s Manual of
Determinative Bacteriology, 9th-edition, Williams & Wilkins, pp 175-189. - Don J. Brenner and J.J. Farmer III, 2001. Family I. Enterobacteriaceae. In: Bergey’s Manual of Systematic Bacteriology, Second
edition, Vol two, part B, George M. Garrity (Editor-in-Chief), pp 587-897. - Farmer III (J.J.) et al.: Escherichia fergusonii and Enterobacter taylorae, two new species of Enterobacteriaceae isolated from
clinical specimens. J. Clin. Microbiol., 1985, 21, 77-81. - Adeolu M, Alnajar S, Naushad S, S Gupta R. Genome-based phylogeny and taxonomy of the 'Enterobacteriales': proposal for
Enterobacterales ord. nov. divided into the families Enterobacteriaceae, Erwiniaceae fam. nov., Pectobacteriaceae fam. nov.,
Yersiniaceae fam. nov., Hafniaceae fam. nov., Morganellaceae fam. nov., and Budviciaceae fam. nov. Int J Syst Evol Microbiol 2016. - Srinivas K., Ghatak S, Pyngrope DA, Angappan M et al., 2023. Avian strains of emerging pathogen Escherichia fergusonii are
phylogenetically diverse and harbour the greatest AMR dissemination potential among different sources: Comparative genomic
evidence. Front. Microbiol. 13:1080677. doi: 10.3389/fmicb.2022.1080677. - Bain M., Green C., 1999. Isolation of Escherichia fergusonii in cases clinically suggestive of salmonellosis. Vet. Rec. 144, 511.
- Maheux AF, Boudreau DK, Bergeron MG and Rodriguez MJ, 2014. Characterization of Escherichia fergusonii and Escherichia albertii
isolated from water. J Appl Microbiol 117, 597-609.
Positive results for catalase, indole production, lysine decarboxylase, methyl red,
nitrate reduction, ornithine decarboxylase, acid production from: L-arabinose,
D-arabitol, cellobiose, D-galactose, glucose (with gas production), D-mannitol,
maltose, rhamnose and trehalose.
Negative results for alkaline phosphatase, arginine dihydrolase, beta-D-glucosidase,
alpha-galactosidase, H2S production, urease, Voges-Proskauer reaction, DN-ase,
lipase, gelatinase, oxidase, phenylalanine and acid production from: erythritol,
glycerol, alpha-methyl-D-glucoside, inositol, melibiose, raffinose, sucrose and
D-sorbitol.
Variable results for citrate utilization, esculin hydrolysis, beta-galactosidase (ONPG),
acid production from dulcitol, salicin, lactose, D-mannose, D-tagatose, adonitol and
D-xylose.
nitrate reduction, ornithine decarboxylase, acid production from: L-arabinose,
D-arabitol, cellobiose, D-galactose, glucose (with gas production), D-mannitol,
maltose, rhamnose and trehalose.
Negative results for alkaline phosphatase, arginine dihydrolase, beta-D-glucosidase,
alpha-galactosidase, H2S production, urease, Voges-Proskauer reaction, DN-ase,
lipase, gelatinase, oxidase, phenylalanine and acid production from: erythritol,
glycerol, alpha-methyl-D-glucoside, inositol, melibiose, raffinose, sucrose and
D-sorbitol.
Variable results for citrate utilization, esculin hydrolysis, beta-galactosidase (ONPG),
acid production from dulcitol, salicin, lactose, D-mannose, D-tagatose, adonitol and
D-xylose.

(c) Costin Stoica

| Antibiogram |
| Encyclopedia |
| Culture media |
| Biochemical tests |
| Stainings |
| Images |
| Movies |
| Articles |
| Identification |
| Software |
| R E G N U M PROKARYOTAE |
| Back |